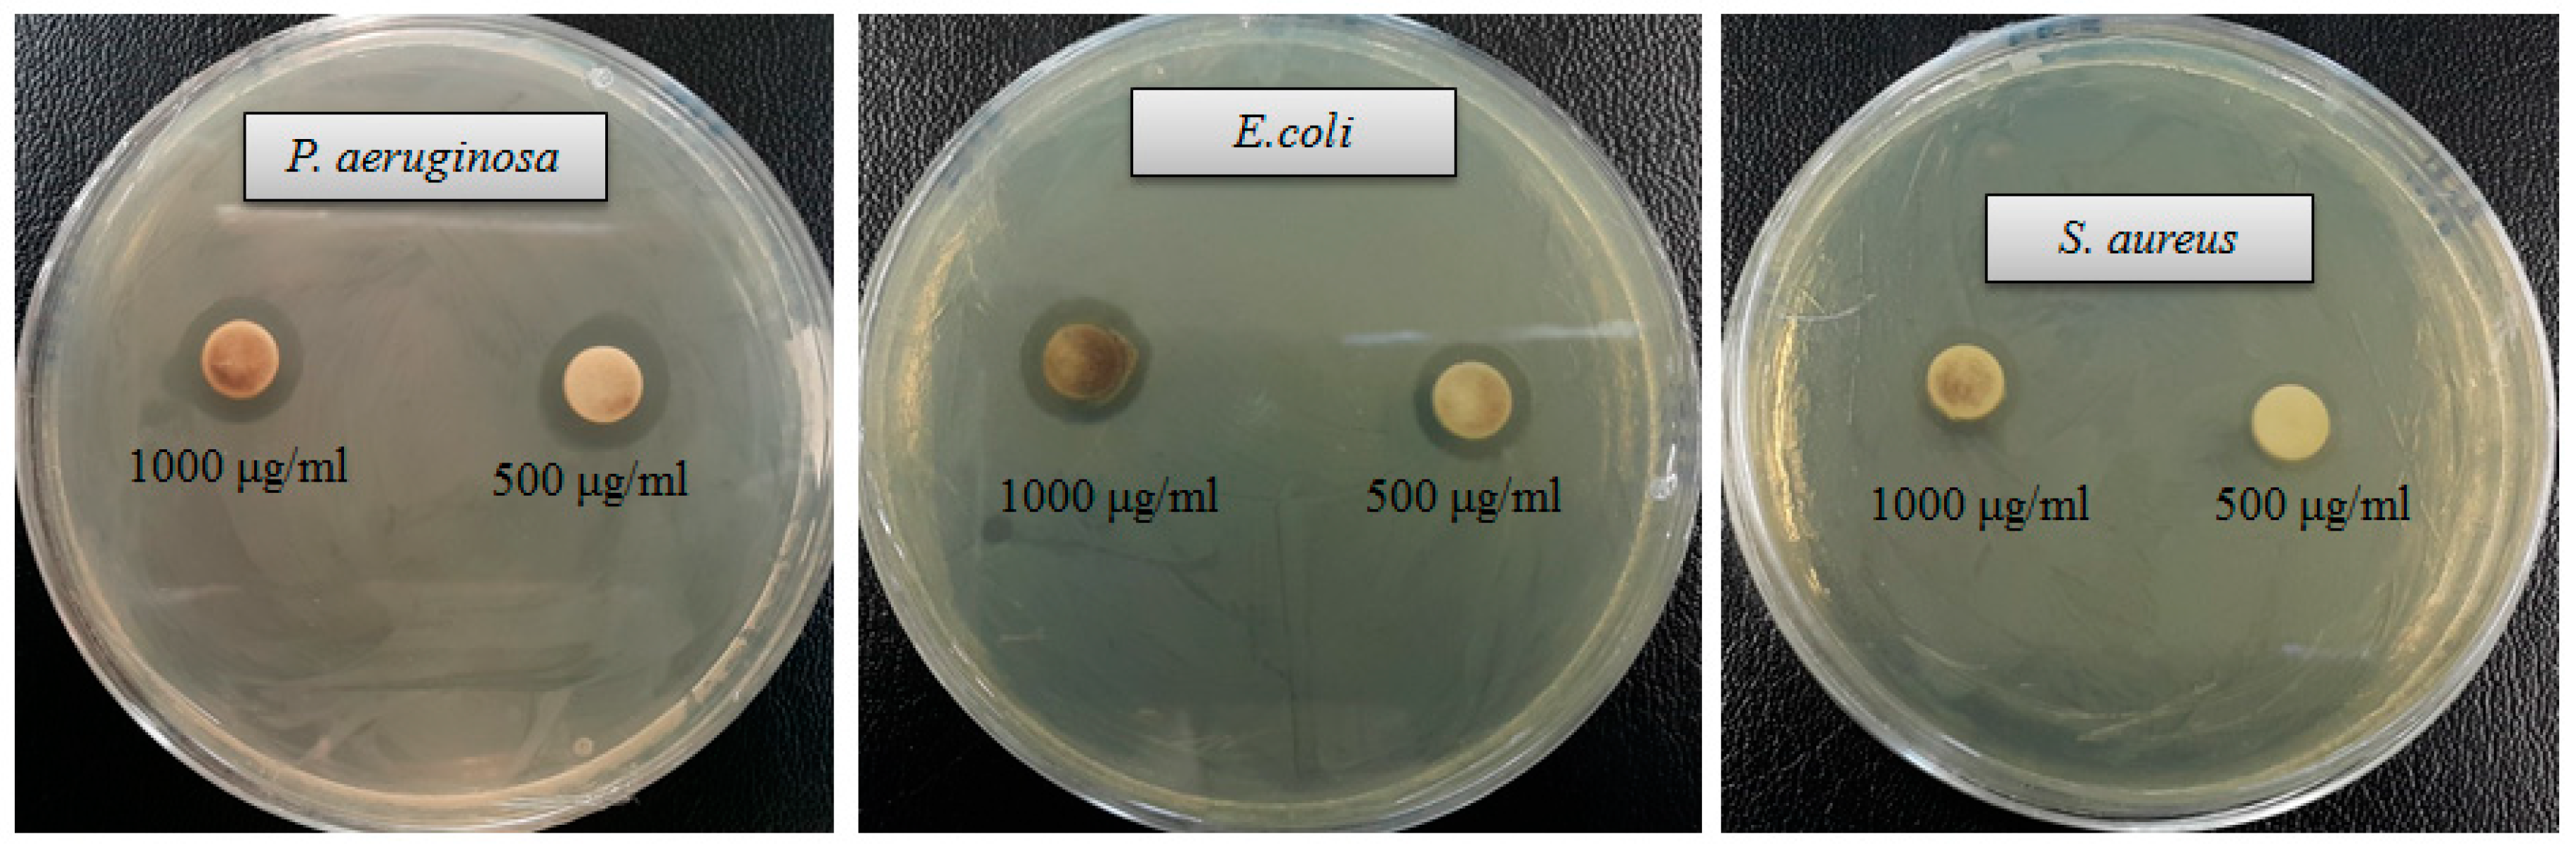
Ijms 21 01510 g007 Ijms 21 01510 g007
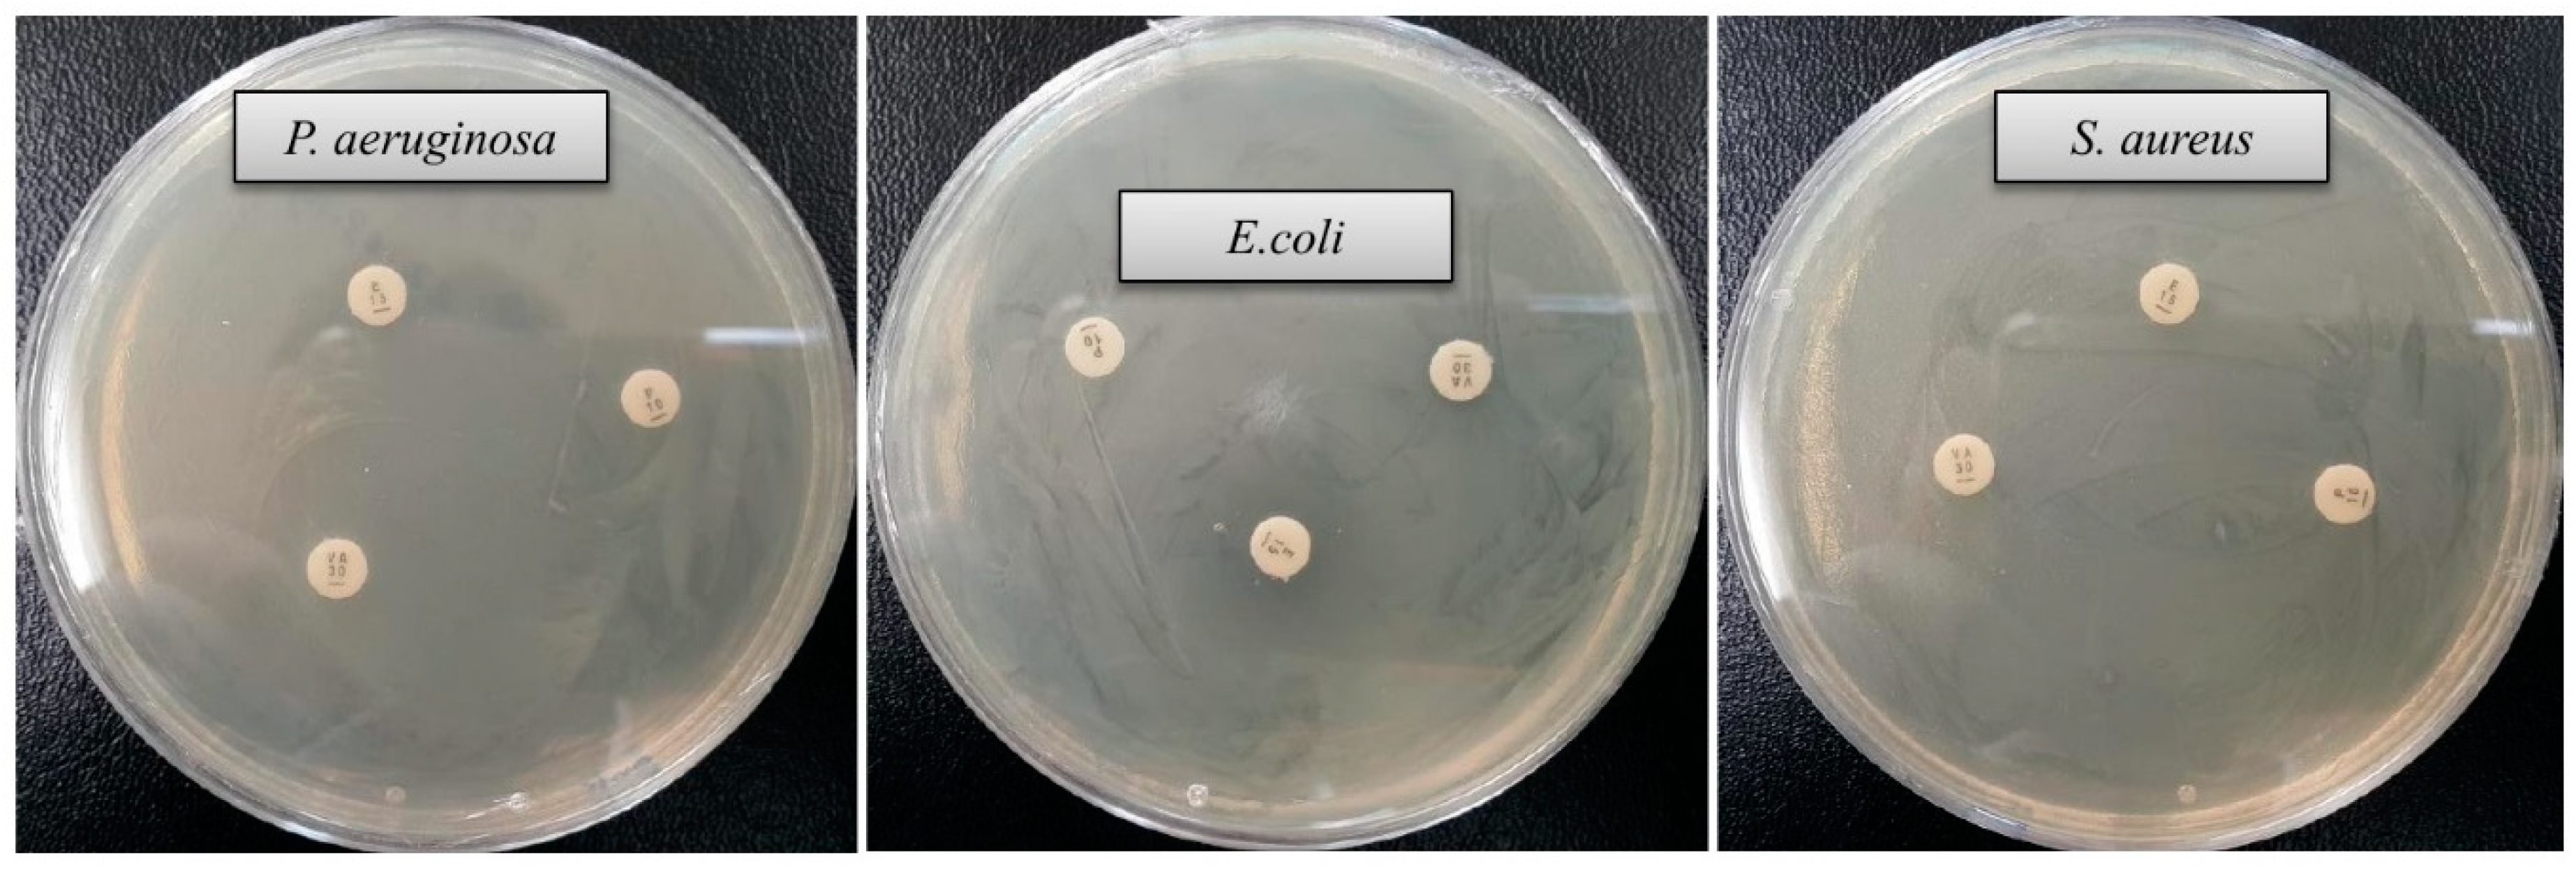
Ijms 21 01510 g008 Ijms 21 01510 g008
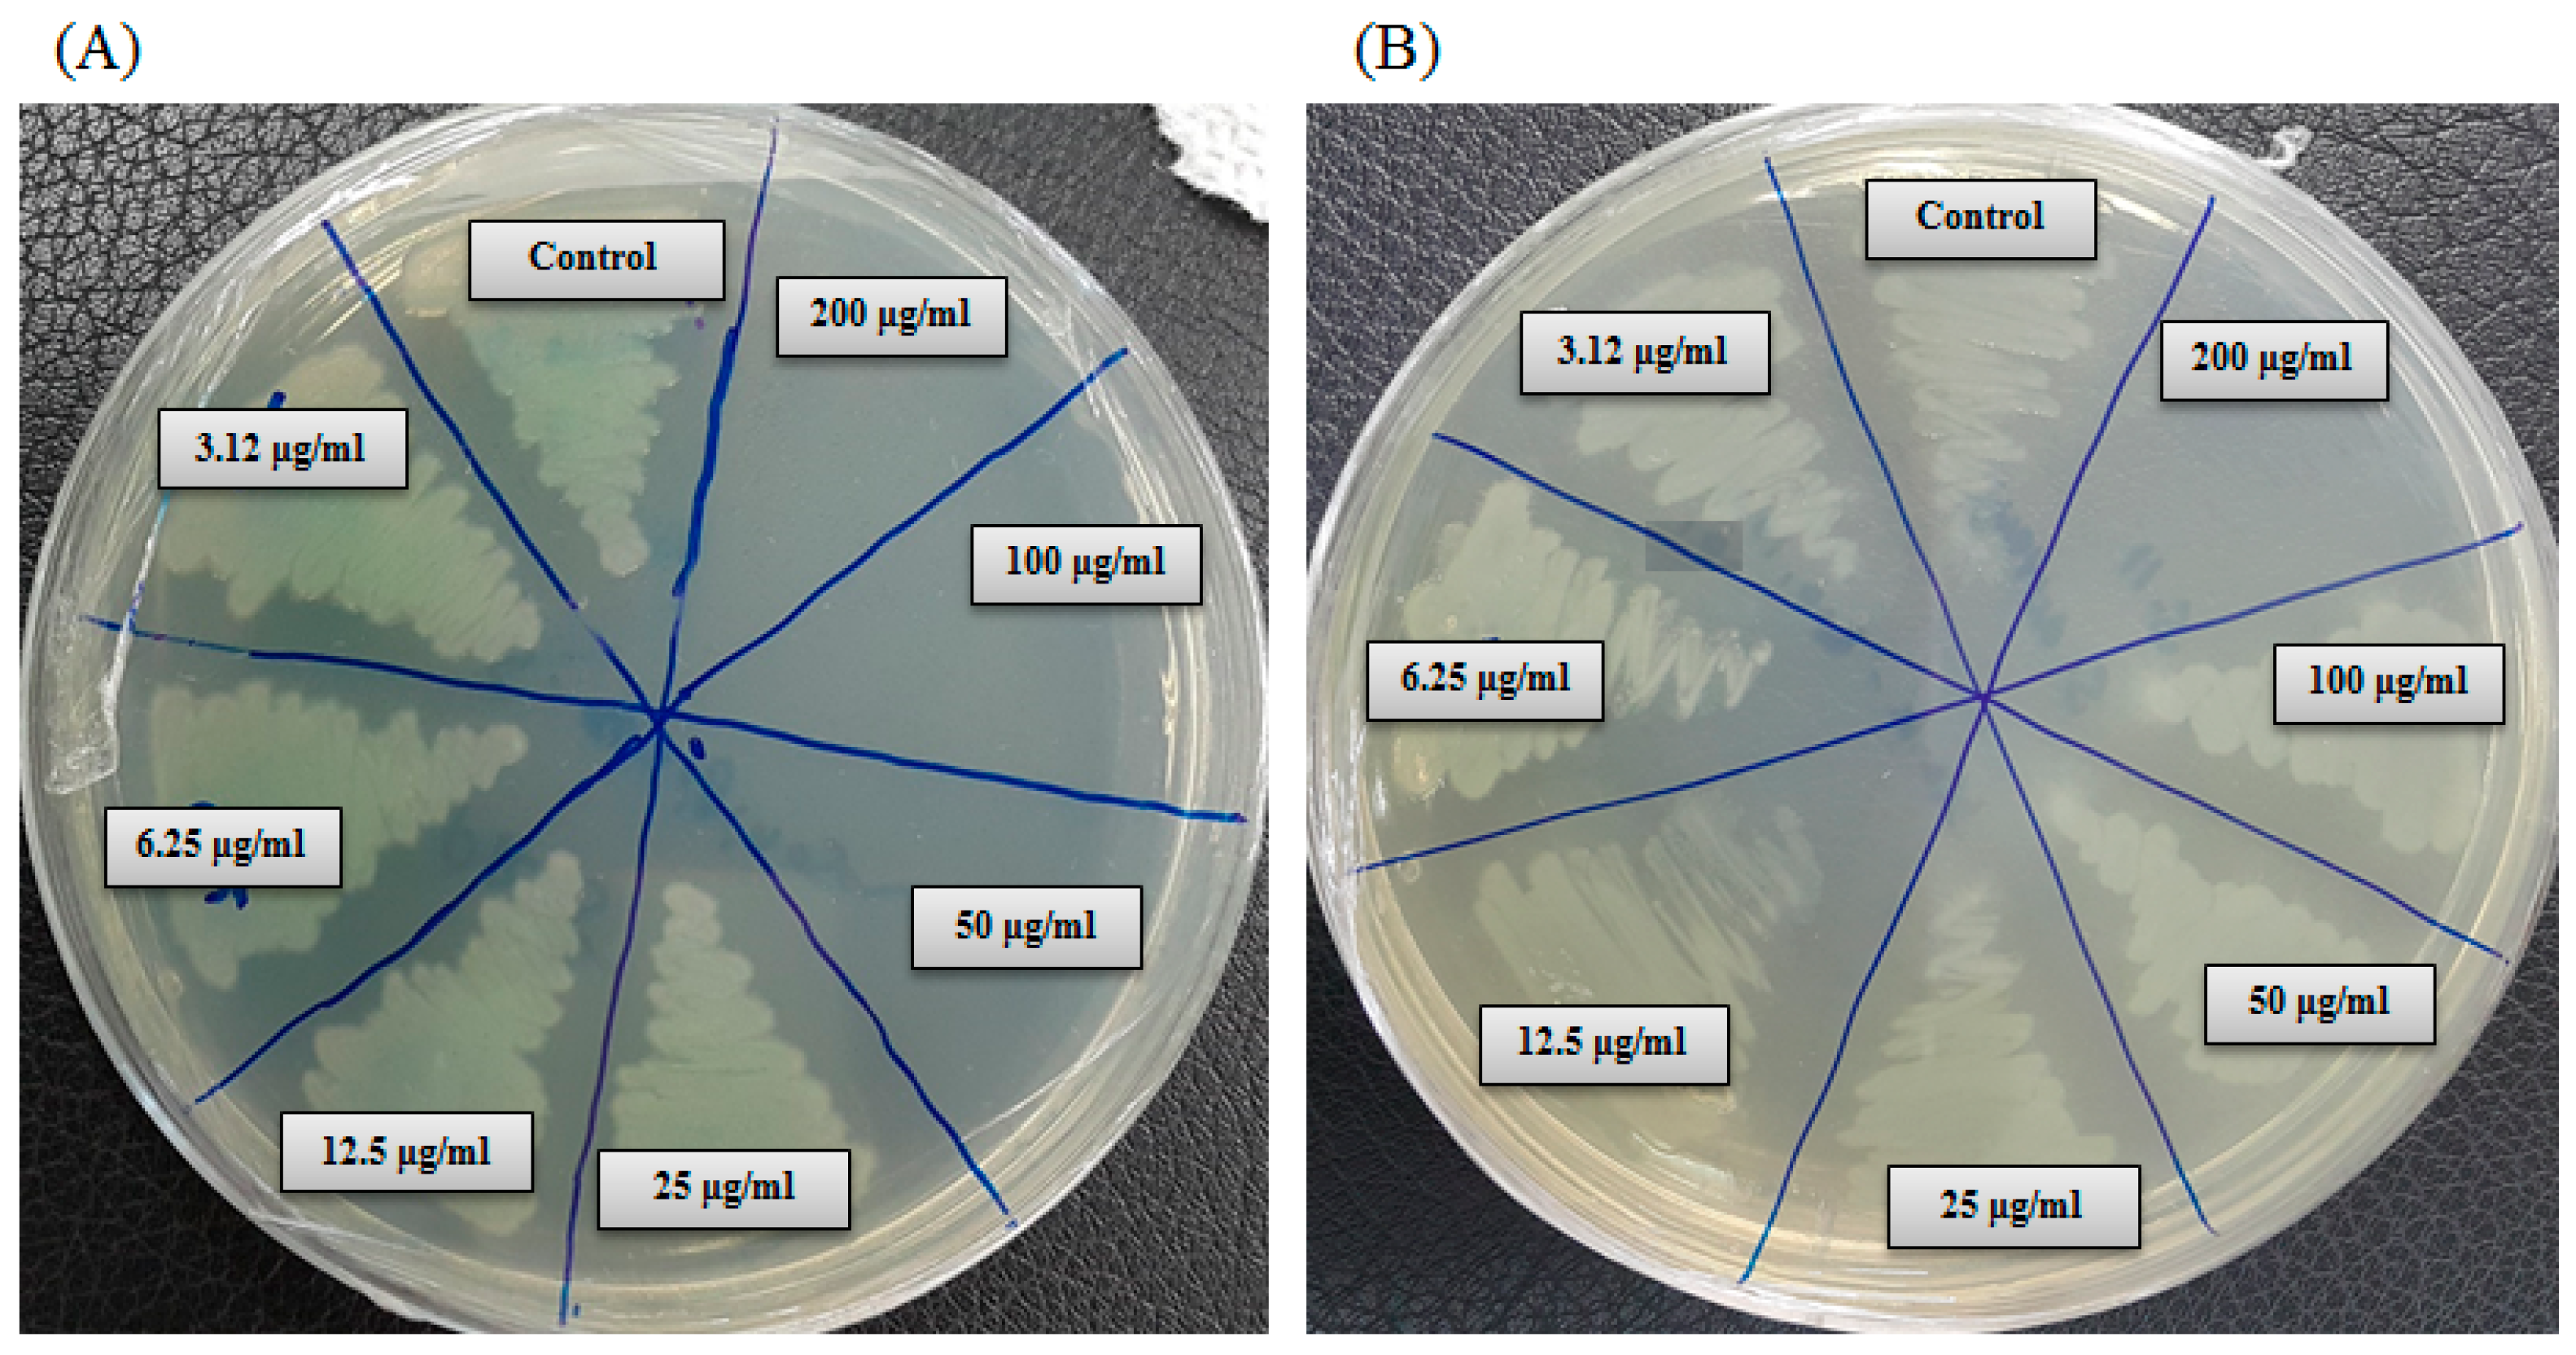
Ijms 21 01510 g010 Ijms 21 01510 g010

Green Synthesis of Silver Nanoparticles Using Pseudoduganella eburnea MAHUQ-39 and Their Antimicrobial Mechanisms Investigation against Drug Resistant Human Pathogens
Abstract
1. Introduction
2. Results and Discussion
2.1. Characterization of AgNPs Producing Bacterial Strain
2.2. Green Synthesis of AgNPs Using Strain MAHUQ-39
2.3. Characterization of Green Synthesized AgNPs
2.4. Antimicrobial Activity of Green Synthesized AgNPs
2.5. Minimum Inhibitory Concentration and Minimum Bactericidal Concentration
2.6. Study of Morphogenesis of Treated Cells by FE–SEM
3. Materials and Methods
3.1. Materials
3.2. Isolation and Identification of Strain MAHUQ-39
3.3. Green Synthesis of AgNPs Using Strain MAHUQ-39
3.4. Characterization of Green Synthesized AgNPs
3.5. Antimicrobial Activity of Green Synthesized AgNPs
3.6. Determination of MIC and MBC
3.7. Investigation of Antibacterial Mechanisms via Study of Morphogenesis of Treated Cells
4. Conclusions
Supplementary Materials
Funding
Conflicts of Interest
References
- Schabes-Retchkiman, P.S.; Canizal, G. Herrera-Becerra R. Biosynthesis and characterization of Ti/Ni bimetallic nanoparticles. Opt. Mater. 2006, 29, 95–99. [Google Scholar] [CrossRef]
- Ahmad, Z.; Pandey, R.; Sharma, S. Alginate nanoparticles as antituberculosis drug carriers: Formulation development, pharmacokinetics and therapeutic potential. Ind. J. Chest. Dis. Allied. Sci. 2006, 48, 171–176. [Google Scholar]
- Singh, P.; Singh, H.; Kim, Y.J. Extracellular synthesis of silver and gold nanoparticles by Sporosarcina koreensis DC4 and their biological applications. Enzym. Microb. Technol. 2016, 86, 75–83. [Google Scholar] [CrossRef]
- Nam, J.M.; Thaxton, C.S.; Mirkin, C.A. Nanoparticle-based bio-bar codes for the ultrasensitive detection of proteins. Science 2003, 301, 1884–1886. [Google Scholar] [CrossRef] [PubMed]
- Parak, W.J.; Gerion, D.; Pellegrino, T. Biological applications of colloidal nanocrystals. Nanotechnology 2003, 14, R15. [Google Scholar] [CrossRef]
- Majdalawieh, A.; Kanan, M.C.; El-Kadri, O. Recent advances in gold and silver nanoparticles: Synthesis and applications. J. Nanosci. Nanotechnol. 2014, 14, 4757–4780. [Google Scholar] [CrossRef] [PubMed]
- Singh, P.; Kim, Y.J.; Singh, H. Biosynthesis, characterization, and antimicrobial applications of silver nanoparticles. Int. J. Nanomed. 2015, 10, 2567–2577. [Google Scholar]
- Zazo, H.; Colino, C.I.; Lanao, J.M. Current applications of nanoparticles in infectious diseases. J. Control. Release 2016, 224, 86–102. [Google Scholar] [CrossRef]
- Farhadian, N.; Mashoof, R.U.; Khanizadeh, S. Streptococcus mutans counts in patients wearing removable retainers with silver nanoparticles vs those wearing conventional retainers: A randomized clinical trial. Am. J. Orthod. Dentofac. Orthop. 2016, 149, 155–160. [Google Scholar] [CrossRef]
- Prabhu, S.; Poulose, E. Silver nanoparticles: Mechanism of antimicrobial action, synthesis, medical applications, and toxicity effects. Int. Nano. Lett. 2012, 2, 1–10. [Google Scholar] [CrossRef]
- Nagasundaram, N.; Rahuman, M.A.; Raghavan, P.S. Antibacterial application studies of nanosilver incorporated products. Int. J. Pharm. Res. Bio–Sci. 2014, 3, 153–164. [Google Scholar]
- Chaloupka, K.; Malam, Y.; Seifalian, A.M. Nanosilver as a new generation of nanoproduct in biomedical applications. Trends Biotechnol. 2010, 28, 580–588. [Google Scholar] [CrossRef] [PubMed]
- AshaRani, P.V.; LowKahMun, G.; Hande, M.P. Cytotoxicity and genotoxicity of silver nanoparticles in human cells. ACS Nano. 2009, 3, 279–290. [Google Scholar] [CrossRef] [PubMed]
- Marambio-Jones, C.; Hoek, E.M. A review of the antibacterial effects of silver nanomaterials and potential implications for human health and the environment. J. Nanopart. Res. 2010, 12, 1531–1551. [Google Scholar] [CrossRef]
- Du, J.; Sing, H.; Yi, T.H. Biosynthesis of silver nanoparticles by Novosphingobium sp. THG-C3 and their antimicrobial potential. Artif. Cells. Nanomed. Biotechnol. 2017, 45, 211–217. [Google Scholar] [CrossRef]
- Rajeshkumar, S.; Malarkodi, C.; Paulkumar, K. Intracellular and extracellular biosynthesis of silver nanoparticles by using marine bacteria Vibrio alginolyticus. J. Nanosci. Nanotechnol. 2013, 3, 21–25. [Google Scholar]
- Velusamy, P.; Kumar, G.V.; Jeyanthi, V. Bio-inspired green nanoparticles: Synthesis, mechanism, and antibacterial application. Toxicol. Res. 2016, 32, 95–102. [Google Scholar] [CrossRef]
- Wang, C.; Kim, Y.J.; Singh, P. Green synthesis of silver nanoparticles by Bacillus methylotrophicus, and their antimicrobial activity. Artif. Cells. Nanomed. Biotechnol. 2016, 44, 1127–1132. [Google Scholar]
- Kumar, S.A.; Abyaneh, M.K.; Gosavi, S.W. Nitrate reductase-mediated synthesis of silver nanoparticles from AgNO3. Biotechnol. Lett. 2007, 29, 439–445. [Google Scholar] [CrossRef]
- Hulkoti, N.I.; Taranath, T.C. Biosynthesis of nanoparticles using microbes–a review. Colloids Surf. B Biointerfaces 2014, 121, 474–483. [Google Scholar] [CrossRef]
- Singh, O.V. Microbial Molecular Mechanisms in Biosynthesis of Nanoparticles. In Bio-nanoparticles: Biosynthesis and Sustainable Biotechnological Implications; Singh, O.V., Ed.; John Wiley & Sons: New York, NY, USA, 2015; p. 61. [Google Scholar] [CrossRef]
- Singh, N.; Khanna, P.K. In situ synthesis of silver nano-particles in polymethylmethacrylate. Mater. Chem. Phys. 2007, 104, 367–372. [Google Scholar] [CrossRef]
- Du, J.; Sing, H.; Yi, T.H. Antibacterial, anti-biofilm and anticancer potentials of green synthesized silver nanoparticles using benzoin gum (Styrax benzoin) extract. Bioprocess. Biosyst. Eng. 2016, 39, 1923–1931. [Google Scholar] [CrossRef] [PubMed]
- Kalishwaralal, K.; BarathManiKanth, S.; Pandian, S.R. Silver nanoparticles impede the biofilm formation by Pseudomonas aeruginosa and Staphylococcus epidermidis. Colloids Surf. B Biointerfaces 2010, 79, 340–344. [Google Scholar] [CrossRef] [PubMed]
- Rehman, S.; Jermy, B.R.; Akhtar, S.; Borgio, J.F. Isolation and characterization of a novel thermophile; Bacillus haynesii, applied for the green synthesis of ZnO nanoparticles. Artif. Cells Nanomed. Biotechnol. 2019, 47, 2072–2082. [Google Scholar] [CrossRef] [PubMed]
- Chatterjee, T.; Chatterjee, B.K.; Majumdar, D.; Chakrabarti, P. Antibacterial effect of silver nanoparticles and the modeling of bacterial growth kinetics using a modified Gompertz model. Biochim. Biophys. Acta 2015, 1850, 299–306. [Google Scholar] [CrossRef]
- Shankar, S.; Rhim, J.W. Amino acid mediated synthesis of silver nanoparticles and preparation of antimicrobial agar/silver nanoparticles composite films. Carbohydr. Polym. 2015, 130, 353–363. [Google Scholar] [CrossRef]
- Kim, J.S.; Kuk, E.; Yu, K.N. Antimicrobial effects of silver nanoparticles. Nanomed. Nanotechnol. Biol. Med. 2007, 3, 95–101. [Google Scholar] [CrossRef]
- Kim, O.S.; Cho, Y.J.; Lee, K. Introducing EzTaxon-e: A prokaryotic 16S rRNA gene sequence database with phylotypes that represent uncultured species. Int. J. Syst. Evol. Microbiol. 2012, 62, 716–721. [Google Scholar] [CrossRef]
- Saitou, N.; Nei, M. The neighbor-joining method: A new method for reconstructing phylogenetic trees. Mol. Biol. Evol. 1987, 4, 406–425. [Google Scholar]
- Tamura, K.; Stecher, G.; Peterson, D. MEGA6: Molecular evolutionary genetics analysis version 6.0. Mol. Biol. Evol. 2013, 30, 2725–2729. [Google Scholar] [CrossRef]
- Ansari, M.A.; Baykal, A.; Asiri, S. Synthesis and characterization of antibacterial activity of spinel chromium-substituted copper ferrite nanoparticles for biomedical application. J. Inorg. Organomet. Polym. Mater. 2018, 28, 2316–2327. [Google Scholar] [CrossRef]

| API 20 NE | Result | API ZYM | Result |
|---|---|---|---|
| Nitrate reduction | + | Alkaline phosphatase | + |
| Indole production | − | Esterase (C4) | + |
| Glucose fermentation | − | Esterase lipase (C8) | w |
| Hydrolysis of | Lipase (C-14) | w | |
| L-arginine | + | Cystine arylamidase | + |
| Urea | − | Valine arylamidase | + |
| Esculine | w | Leucine arylamidase | + |
| Gelatine | − | Trypsin | + |
| 4-nitrophenyl-BD-galactopyranoside | + | α-chymotrypsin | w |
| Utilization of | Acid phosphatase | + | |
| D-glucose | + | Naphthol-AS-BI-phosphohydrolase | + |
| D-mannitol | + | α-galactosidase | + |
| L-arabinose | + | β-galactosidase | + |
| D-mannose | + | β-glucuronidase | − |
| D-maltose | + | α-glucosidase | + |
| N-acetyl-glucosamine | + | β-glucosidase | + |
| Gluconate | + | N-acetyl-β-glucosaminidase | + |
| Adipic acid | − | α-mannosidase | w |
| Capric acid | w | α-fucosidase | w |
| Malic acid | + | ||
| Triosodium citrate | w | ||
| Phenylacetic acid | + |
| Pathogenic Species | Zone of Inhibition (mm) | |
|---|---|---|
| 1000 μg/mL | 500 μg/mL | |
| Escherichia coli [ATCC 10798] | 16.1 ± 1.5 | 13.9 ± 0.8 |
| Pseudomonas aeruginosa [ATCC 10145] | 16.6 ± 1.3 | 15.1 ± 1.0 |
| Staphylococcus aureus [ATCC 6538] | 13.4 ± 0.7 | 11.6 ± 1.1 |
| Pathogenic Species | Antibiotic | Zone of Inhibition (mm) |
|---|---|---|
| Escherichia coli [ATCC 10798] | Erythromycin Vancomycin Penicillin G | - - - |
| Pseudomonas aeruginosa [ATCC 10145] | Erythromycin Vancomycin Penicillin G | - - - |
| Staphylococcus aureus [ATCC 6538] | Erythromycin Vancomycin Penicillin G | - - - |
© 2020 by the author. Licensee MDPI, Basel, Switzerland. This article is an open access article distributed under the terms and conditions of the Creative Commons Attribution (CC BY) license (http://creativecommons.org/licenses/by/4.0/).
Share and Cite
Huq, M.A. Green Synthesis of Silver Nanoparticles Using Pseudoduganella eburnea MAHUQ-39 and Their Antimicrobial Mechanisms Investigation against Drug Resistant Human Pathogens. Int. J. Mol. Sci. 2020, 21, 1510. https://doi.org/10.3390/ijms21041510
Huq MA. Green Synthesis of Silver Nanoparticles Using Pseudoduganella eburnea MAHUQ-39 and Their Antimicrobial Mechanisms Investigation against Drug Resistant Human Pathogens. International Journal of Molecular Sciences. 2020; 21(4):1510. https://doi.org/10.3390/ijms21041510
Chicago/Turabian StyleHuq, Md. Amdadul. 2020. "Green Synthesis of Silver Nanoparticles Using Pseudoduganella eburnea MAHUQ-39 and Their Antimicrobial Mechanisms Investigation against Drug Resistant Human Pathogens" International Journal of Molecular Sciences 21, no. 4: 1510. https://doi.org/10.3390/ijms21041510
APA StyleHuq, M. A. (2020). Green Synthesis of Silver Nanoparticles Using Pseudoduganella eburnea MAHUQ-39 and Their Antimicrobial Mechanisms Investigation against Drug Resistant Human Pathogens. International Journal of Molecular Sciences, 21(4), 1510. https://doi.org/10.3390/ijms21041510




